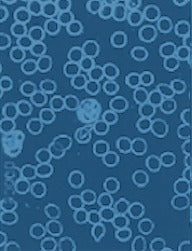

The Foundation of Wellness
Enduring well-being starts with your cells. PureWave is on the cutting edge of Coherence technology that supports cellular health. It’s not just about having a long life. It’s about having a life worth living today.


Enduring well-being starts with your cells. PureWave is on the cutting edge of Coherence technology that supports cellular health. It’s not just about having a long life. It’s about having a life worth living today.

Think of your body like a symphony orchestra.
Every instrument (your cells) must be in tune and play in sync to create beautiful music. If even a few instruments are out of tune or off-tempo, the entire performance suffers.
When your cells fall out of Coherence, your body’s systems become less efficient, and the symphony falls apart.

Cooperates with its neighboring cells
Absorbs the nutrients it needs and eliminates waste effectively
Generates enough energy to keep the whole process going
This state of Coherence supports healthy energy levels, excellent recovery, and natural resilience—the foundation for long-term wellness and quality of life.

Imagine a city where the traffic lights stop working. Cars pile up at intersections, deliveries get delayed, and everything slows to a halt.
That’s similar to what happens inside your body when Coherence breaks down—communication pathways are compromised, nutrients don’t enter cells as efficiently, waste builds up, and energy production declines.
The result? Overall well-being suffers.
Factors that can contribute to Incoherence include:
Over time, factors like these accumulate, making it harder for your body to maintain balance and perform at its best.
Using tens of thousands of frequencies targeting every tissue type in your body, PureWave is designed to promote many cellular activities like nutrient absorption and energy production.
The Coherent frequencies produced by PureWave are aimed at harmonizing and synchronizing your cells, just like a school of fish or a flock of birds.



01
PureWave emits precise electromagnetic frequencies through a specially designed coil in the full-body mat, and through other applicators like the Target Pad, the Hoggle, and the Swirl.
These frequencies are fine-tuned to complement the body’s natural energy systems. Cells respond to these frequencies like a tuning fork vibrating in resonance when you play certain musical notes.
02
Each of your body’s cells has tiny receptors on its surface, like security checkpoints that control what goes in and what goes out.
These receptors regulate critical cell functions such as the efficient movement of nutrients and waste products in and out of the cell.
PureWave PEMF aims to support this process, which is influenced by the cell’s electrical environment, by exposing your cells to the right frequencies.
03
Inside each cell, tiny structures called mitochondria act like power stations, generating the energy your body runs on.
When cells are weak or damaged, these power stations produce less energy.
PureWave PEMF targets healthy mitochondrial activity and increased cellular energy.
Studies have shown that when cell voltage increases, mitochondria multiply, giving your body even more energy over time.
04
When all of these processes work together—nutrient uptake, waste removal, and energy production, among others—your cells are in Coherence.
The state of Coherence is characterized by improved recovery, resilience against environmental stressors, and overall well-being.
80-900% in 10 minutes

After Session

Before Session

Before Session

After Session
Separate in 10 minutes

Before Session

5 Mins
15 Mins

Hours After

Feel awake and alert throughout your day. Whether you’re a busy professional struggling with mid-afternoon crashes, a parent keeping up with energetic kids, or someone looking for the stamina to hit the gym after work, increased energy means you can do more and feel great doing it.
Bounce back faster from workouts, long workdays, or travel fatigue. Whether you’re an athlete recovering from intense training or simply want to wake up without lingering soreness, faster recovery helps you stay active and perform at your best every day.
Struggle with winding down at night? Coherence in body and brain promotes deeper relaxation, helping you fall asleep faster and wake up feeling refreshed. No more tossing and turning—just quality rest that leaves you ready to take on the day.
When your cells function optimally, it supports everything from digestion and metabolism to skin health and overall resilience. Coherence helps you stay vibrant and feeling youthful for years to come.

Your body is designed for balance.
When your cells are in sync, you feel strong, clear-minded, and resilient. And when you feel that way, life is just better. PureWave helps support this natural state.
Discover a new level of Coherence and unlock your full potential.